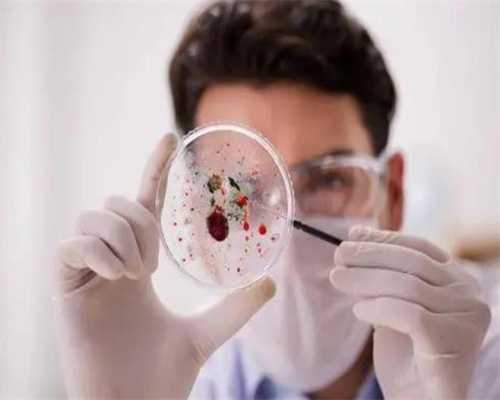
浙江供卵贵么,舟山妇女的童医院试管流程分享_舟山妇女儿童医院预约挂号！

浙江供卵贵么,舟山妇女的童医院试管流程分享_舟山妇女儿童医院预约挂号!
发布时间:2025-05-26 浏览量:381次
舟山妇儿医院试管流程分享:试管助孕流程多。舟山市妇儿医院开展的试管助孕技术相对来说比较成熟,其成功率在50%左右,如果患者确实存在输卵管堵塞、少精症和弱精症等情况,那么可以携带夫妻双方的身份证、结婚证、不孕不育证明等证件到医院申请试管助孕,助孕的流程相对来说比较多,可以分为检查、促排取卵、养胚移植等步骤。
周山妇儿医院经过多年的发展,其辅助生殖技术已经得到了众多患者的认可,只是辅助生殖技术并不是万能的,只要是手术,都存在一定的失败风险,所以在辅助生殖时一定要积极进行身体调理,同时做好心理准备。
试管流程详解 不孕不育患者到舟山市妇女儿童医院做试管 助孕的过程并不是很复杂,主要分为前期检查、排卵、取卵取精、体外受精、胚胎培养、胚胎移植这六个步骤,但是每个患者的身体情况不同,助孕的方案也或多或少存在差异,所以具体的过程中存在细微的差别是很 在具体的过程中存在细微的差别是很正常的。
试管流程详解 不孕不育患者到舟山市妇女儿童医院做试管 助孕的过程并不是很复杂,主要分为前期检查、排卵、取卵取精、体外受精、胚胎培养、胚胎移植这六个步骤,但是每个患者的身体情况不同,助孕的方案也或多或少存在差异,所以具体的过程中存在细微的差别是很 在具体的过程中存在细微的差别是很正常的。以上就是关于 “舟山妇儿医院试管流程分享,舟山妇儿医院试管生宝宝流程 ”的相关内容介绍,目前国内的试管助孕试管机构鱼龙混杂,但正规可靠的民营试管生宝宝医院也不在少数,患者应根据自身需求选择合适的医疗机构。如果您有高龄二胎、未婚试管、女性子宫疾病试管、男性少精症试管等试管需求,可以免费咨询我们的生育顾问!



